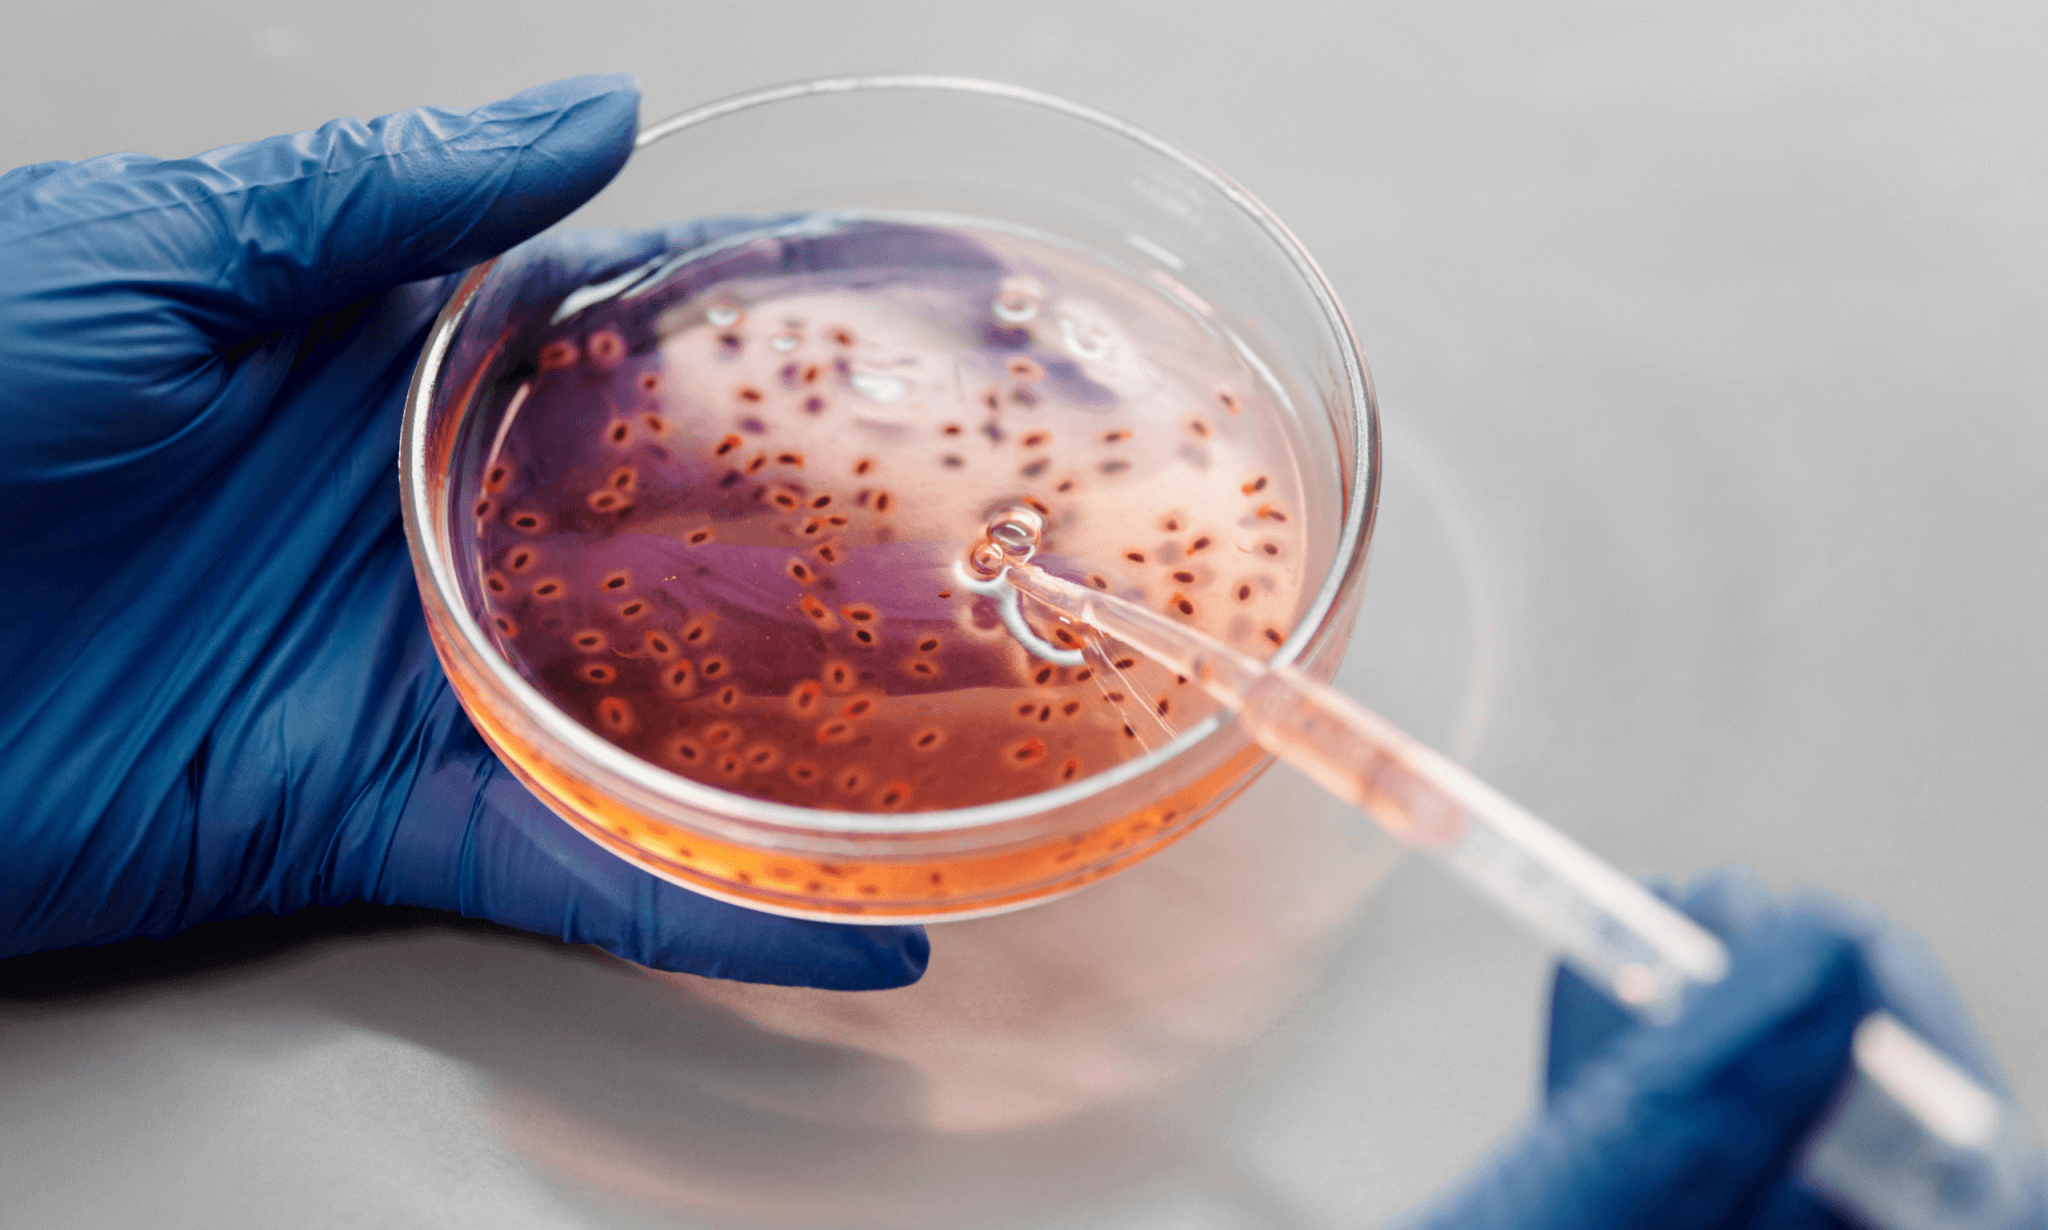
FlipBox

EAH Jena

– TOOLS –
Uniting optics, photonics, and clinical research, this project bridges basic science and medical application to pioneer optical technologies for understanding and diagnosing biomedical processes.

– OptoCarDi –
This project is developing a groundbreaking multimodal imaging catheter to diagnose myocarditis without risky biopsies, enabling precise, marker-free insights into heart muscle disease.

– OpenLabKI –
OpenLab KI is building a cross-domain AI framework that transforms optical image data into insights for medicine and manufacturing—while training the next generation of data-savvy scientists.

– EasyPROBE –
By fusing cutting-edge optical methods into a single endoscopic probe, this project paves the way for faster, gentler, and more precise cancer diagnostics.

– ZAKI – HyperVismo –
This project drives interdisciplinary AI innovation: from medical imaging to industrial optimization, while training young scientists to turn regional challenges into real-world solutions.

– OpenLab for OCT –
The OpenLab for OCT harnesses cutting-edge 3D imaging to advance biomedical diagnostics and non-destructive testing, while building a hub for research and industry collaboration.

– OCToScope –
OCToScope develops a multimodal optical imaging system combining OCT, MSI, and microscopy for precise, non-invasive diagnosis of middle ear diseases.
Leibniz IPHT

– LPI-BT1 –
Combines multimodal optical imaging techniques to visualize infection processes across biological scales with molecular precision.
– Gelbert-Stiftung –
Applies Raman spectroscopy to ensure the quality and safety of genetically modified cells for regenerative medicine.

– YELLOW –
Yellow develops dysprosium-based fiber lasers and background-free multimodal fiber probes to enable high-precision Raman spectroscopy in the previously inaccessible yellow spectral region.
Finished Projects
EAH Jena
Leibniz IPHT

– INTACT –
This project pioneered a miniaturized sensor-pump system to continuously monitor nutrient uptake in premature infants, aiming for safer treatments and healthier development.

– InfectoXplore –
By harnessing on-chip Raman spectroscopy, researchers are creating a fast and affordable tool to identify infections and antibiotic resistance in critically ill patients within hours.

– MIB –
Brings real-time cancer diagnostics into the operating room through Raman-based endoscopic imaging.

– LPI-BT2 –
Accelerates point-of-care diagnostics through photonic interaction assays that reveal antibiotic resistance in record time.
